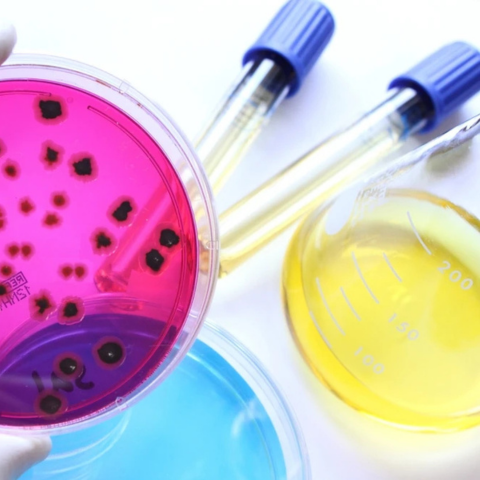
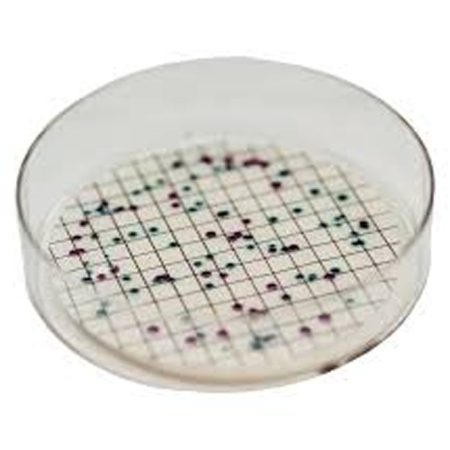
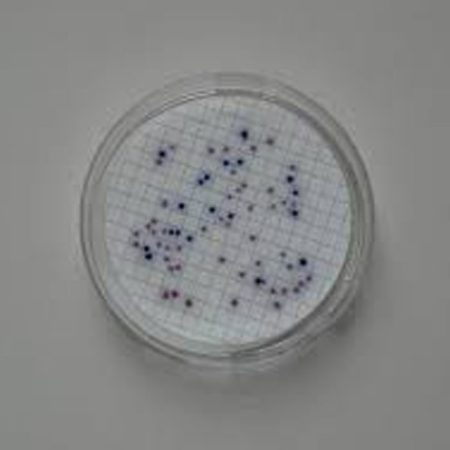

Servicio Técnico.
Entrega Rápida
Entrega segura de sus pedidos
Pago Seguro
Pagos seguros y confiables
Calidad Garantizada
En producto y Servicios
Departamento Técnico
Reparaciones de Equipo
Lo más nuevo por categoría
Desde 1978
Distribuidora de Laboratorio y Equipo Institucional, S.A.
Desde 1978 atendiendo dos divisiones principales: Clínica e Industria. Cubrimos el país gracias al equipo de asesores que han sido capacitados directamente de las casas fabricantes, ofreciéndoles así a nuestros clientes una atención especializada. Equipos de laboratorio y mucho más.

Últimas Noticias
Purificación automatizada de ácidos nucleicos | Maxwell + Quantus #1
🧬 Purificación de ácidos nucleicos sin interrupciones: Maxwell + Quantus, la dupla #1 para automatizar tu laboratorio Purificación automatizada de ácidos nucleicos | Maxwell + Quantus #1 Automatice, cuantifique y optimice sus muestras de ADN y ARN con máxima reproducibilidad y precisión. En biotecnología, la eficiencia y la confiabilidad son esenciales para obtener resultados […]
Puntas para micropipetas NovasBio: (2025) La guía definitiva de calidad y rendimiento
Qué son las puntas para micropipetas NovasBio Las puntas para micropipetas NovasBio son insumos esenciales en el manejo de líquidos dentro del laboratorio. Su diseño universal garantiza ajuste, precisión y seguridad con la mayoría de marcas de pipetas automáticas.En DILAB, proveedor líder de equipos de laboratorio en Guatemala, incorporamos esta marca a nuestro portafolio por […]
Mantenimiento y Calibración de Pipetas en Guatemala – 5 Razones poderosas para Confiar en el SPA de DILAB
SPA de Pipetas DILAB – mantenimiento y calibración de pipetas profesional para Resultados Confiables Cuida la precisión de tus resultados con el mantenimiento y calibración de pipetas del SPA de Pipetas DILAB. Servicio técnico especializado en Guatemala bajo norma ISO 8655. Agenda tu cita y garantiza mediciones confiables todo el año. En DILAB entendemos que […]